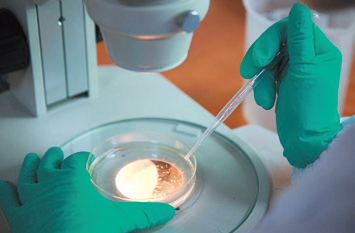

荣格工业资源APP
了解工业圈,从荣格工业资源APP开始。
3 月 18-20 日,中国国际化妆品、个人及家庭护理用品原料展览会(PCHi 2026)将在杭州大会展中心举行,预计超过 800 家企业参展。《happi China》特向参展企业征集展品信息,并根据展商投稿整理出本期展品预览专题。
*节选部分投稿展品,按公司首字母排序
原料供应商
亚什兰:eternight 线粒体长寿焕肤活性成分
展位号:2F36

基于miobiology线粒体生物学研究,发现具有“普适”特性的线粒体长寿驮 humanin。全新活性成分 eternightbioftuncional 灵感源自鸢尾花,依托PSR技术平台与生物信息
学,靶向激活肌肤「3R」长寿机制。28天临床测试显示,可逆转肌肤视觉年龄达4岁(平均改善1.2岁),淡化皱纹,焕活肤色,重塑紧致状态。
电话/Tel:02160906606
电邮/Email:info@ashland.com
网址/Web:www.ashlandchina.com
安赛搏:植物细胞外泌体规模化培养技术
展位号:7L59

依托自主知识产权的植物细胞规模化培养平台,实现天山雪莲、高山火绒草、滨海刺芹愈伤组织规模化培养。通过上清液一步收集植物细胞外泌体,无需组织破碎处理,解决传统植物外泌体制备效率低、稳定性差、杂质多等问题,同时避免动物及微生物来源的免疫原性风险。
电话 / Tel:15311589231
电邮 / Email:pzhuang@acelbio.cn
网址 / Web:http://www.acelbio.cn/
奥利实业:Cellpolypid 细胞磷脂仿生材料
展位号:2F52

以磷酰胆碱聚合物为核心结构的仿生高分子材料,分子构型与人体细胞膜高度相似,该技术入围工信部生物医学领域“揭榜挂帅”项目。基于自主专利技术实现从医用级生物材料向化妆品领域的跨界转化,可在皮肤表面构建仿生界面,提供深层修护、长效保湿功效,适用于医美周期、敏感肌及屏障受损场景。
电话 / Tel:021-64830020
电邮 / Email:oli@olibio.com
网址 / Web:https://www.olibio.com/
百开盛:OmniPure 甘蔗源生物发酵角鲨烷
展位号:7D78-3

基于合成生物技术,以甘蔗为原料经酵母发酵获得高纯角鲨烯,一步加氢制得角鲨烷,纯度≥97%。产品无色无异味,亲肤性好,具有保湿滋润、修护屏障、软化角质等功效。相比传统动植物来源,生物发酵路线可减少资源依赖,符合纯净美容与可持续发展趋势。
电话 / Tel:18521420446
电邮 / Email:jiaying.li@biocatsyn.com
网址 / Web:www.biocatsyn.com
佰鸿华湙:聚苷泰益生菌超组装 PDRN
展位号:2F12

采用自主研发的层叠微球化控释技术,将益生菌来源 PDRN 通过超分子智组装形成纳米级微球,突破传统 PDRN 依赖注射的应用瓶颈。每个超组装单元含 70 万个 PDRN 分子,透皮性能较普通益生菌 PDRN 提升 53%,抗炎因子 IL-10 提升约 1480%,M2 型巨噬细胞标记物 Arg-1 表达量提升约 271%。
电话 / Tel:13409175787
电邮 / Email:455327746@qq.com
网址 / Web:http://www.huayi-sci.com/
柏垠生物:重组贻贝粘蛋白
展位号:6F38

以海洋贻贝足丝蛋白序列为蓝本,通过合成生物技术精准重建其黏附、抗炎与组织修复特性。富含 DOPA 结构域的粘附序列可在湿性环境中实现高强度生物黏附,稳定创面微环境。可快速抑制炎症级联反应,促进成纤维细胞与角质细胞迁移增殖。依托工程菌细胞工厂实现低内毒素、高稳定表达与绿色生产。
电话 / Tel:0755-29870184
电邮 / Email:contact@pam2l.net
网址 / Web:http://www.pam2l.com
毕克化学:个人护理与家居护理助剂
展位号:8F16

展出多款高性能助剂,覆盖护肤、护发、彩妆、防晒及家居护理领域。个护方向包括天然菜籽油来源微粉化蜡 PURABYK-W 5560 BOOST、流变调节剂 RHEOBYK-7590 PC 和 TIXOGEL-CCT,以及赋予丝绒肤感的 PURABYK-P 5541 SATIN。家居护理方向展示 AQUACER 系列涂层助剂,可提升硬度、耐磨性与光泽度。
电话 / Tel:37498888
电邮 / Email:cathline.guo@altana.com
网址 / Web:www.byk.com
碧恩生物:BEN-064 薏仁发酵亮肤素
展位号:6C06

与北京化工大学联合研发,以贵州兴仁薏仁米为原料发酵制得。产品含高活性薏苡素 330μg/ml,氨基酸含量为日本同类竞品 11 倍,自由基清除率为同类竞品 4.4 倍。第三方测试显示,5% 浓度下肤色亮度提升 11.06%,酪氨酸酶抑制率达 55.38%,糖化终产物抑制率达 77.01%。
波顿:植光盾酶促仿生抗光老化成分
展位号:2F12

运用酶促仿生合成技术,将大豆油与阿魏酸精准结合,开发出覆盖皮肤抗光损伤通路的活性成分。在转录层面抑制黑色素激活相关基因(MITF、TYR、TRP-1),从源头减少黑色素合成,实现日间抗光老化与夜间修护提亮的全时段护理方案。
电话 / Tel:13771157340
电邮 / Email:li_yuan@boton.com.cn
网址 / Web:http://bio.boton.com.cn/
博驰生物:多款创新功效原料
展位号:3A27

展出多款创新原料,包括:Exometics G 莱茵衣藻来源仿生囊泡,含 109 种脂质、1369 种蛋白质;NIO-OXY 桑枝精粹植萃美白原料,采用柔性体包裹技术提升渗透性;Hyperpure-MVA 发酵来源甲瓦龙酸内酯;高纯度鼠尾草酸(>90%);以及 CapsuRet HC 高浓度微胶囊包裹视黄醇,具备耐光照、耐高温特性。另有 PhotoGel 凝时因光响应成膜原料。
电话 / Tel:15915730795
电邮 / Email:jerry@gzbochi.com
网址 / Web:www.bochi-bio.com
创健医疗:重组小分子弹性蛋白
展位号:7F24

采用合成生物学技术生产,富含 VGVPG、GXXPG、KXXK 等多个活性片段,小分子结构更易渗透。可显著促进弹性蛋白核心成分 Elastin 及关键组装蛋白 Fibrillin-1、LOX、Fibulin-4/5、LTBP-4 表达,同时抑制弹性蛋白降解酶 MMP-12 活性,实现促进合成与抑制降解的双效协同。真核酵母菌发酵生产,无动物源风险。
电话 / Tel:18651962626
网址 / Web:www.trautec.com.cn
黛丽可:透皙原重组 III 型人源化胶原蛋白
展位号:6F16

依托中国科学技术大学先进技术研究院研发,通过 AI 与合成生物学结合医药级纯化工艺制得。搭载精准透皮递送系统,透皮效率较动物胶原提升 320%,渗透深度可达 100μm。人体临床数据显示使用 28 天后皮肤含水量提升 59.3%,皱纹面积减少 8.96%,毛孔优化 72.08%。
电话 / Tel:15755149895
电邮 / Email:798855823@qq.com
网址 / Web:http://daylike.cn
和晨生物:美芯球纳米组装稳态递送技术
展位号:以现场为准

以纳米组装稳态递送技术为核心,通过超分子结构实现活性成分 90% 以上孔隙率精准搭载。采用行业首创 -196℃ 液氮秒冻锁鲜工艺,全流程低温生产锁定成分活性。结合合成生物学来源活性原料(麦角硫因、茶氨酸、PDRN、根皮素等),产品不添加防腐剂、乳化剂、稳定剂。
电话 / Tel:13817051628
电邮 / Email:zhouweizheng@hcbioworkx.com
华熙生物:Hymagic-VCHA 抗坏血酸透明质酸酯
展位号:2F36

全球创新活性成分,将维生素 C 与透明质酸通过专利工艺精准结合,已完成国内新原料备案(抗坏血酸丙基透明质酸酯钠交联聚合物)并申请新 INCI 名称。选取 VC 3 位羟基与 HA 羧基形成化学键,取代度 5.0%-20.0%,无游离 VC 单体。相较单独 VC 细胞毒性更低,光热稳定性更优,可增强胶原蛋白合成、降低 MMP-1 表达。
电话 / Tel:+86 16622806517
电邮 / Email:fukx@bloomagebiotech.com
网址 / Web:https://www.bloomagebiotech.com/brand.html
斗来:Biorex 小分子山茶籽油
展位号:8E31

采用专有 Ez-Select 酶解技术,将山茶籽油甘油三酯转化为单/双甘油酯,获得小分子结构。相比传统山茶籽油,肤感更清爽不油腻,可提升精华油类产品的轻盈质感,促进亲脂性活性物有效递送,并改善配方乳化性能。
电话 / Tel:+86 21-3988-0562
电邮 / Email:marketing@durae.co.kr
网址 / Web:www.durae.co.kr
泛海精细化工:NB-527 青蒿提取物
展位号:2C12

通过专利提取技术精准保留青蒿中具有驱蚊活性的天然成分,可干扰蚊虫嗅觉感知,实现长效温和驱避。相比传统化学驱蚊剂低刺激、高亲肤,适用于户外防护乳液、清凉啫喱等产品。经验证还具有抗炎抑菌功效,可促进兜甲蛋白与丝聚蛋白表达,巩固皮肤屏障。
电话 / Tel:020-86337218
电邮 / Email:2407177973@qq.com
网址 / Web:https://www.noblebc.cn
弗曼生物:ForPeptide GG 毛孔收缩肽
展位号:8E31

基于皮肤细胞离子稳态机制开发的功效原料(INCI:二肽-15),通过激活氯离子通道稳定细胞内离子平衡,改善因游离不饱和脂肪酸引起的角化不全导致的毛孔粗大问题。产品水溶性好、分子量小,适用于控油祛痘、毛孔紧致等功效型护肤品,兼容敏感肌配方体系。
电话 / Tel:13076870804
电邮 / Email:neve@gzyujin.com.cn
海明斯:高性能增稠流变助剂
展位号:6K28

展出高透明度、高粘度增稠流变助剂,具有优异的增稠触变性能。采用专利合成工艺,不含重金属与致癌物,分散性好,悬浮性能稳定,适用于多种个人护理配方体系。
电话 / Tel:18260034587
电邮 / Email:jacob@hemings.net
网址 / Web:www.jshemings.net
禾元生物:水稻来源重组人血清白蛋白
展位号:C17

利用水稻胚乳细胞生物反应器全球首创实现重组人血清白蛋白高效表达,表达量高达 20g/kg(糙米)。产品无动物源、人血液来源病毒和支原体污染风险,基因序列、氨基酸序列及一级至高级结构与人体 100% 一致。具有舒缓抗敏、祛红修护、抗氧化功效,同时可作为活性成分载体实现运载、递送和保护功能。
电话 / Tel:15201040528
华酵生物:生物发酵护肤原料系列
展位号:3H48

以生物发酵技术为核心,展出三大类原料:二裂酵母系列含纯发酵溶胞产物及黑莓、大豆等复配活性复合物;植物发酵系列涵盖铁皮石斛、人参根、鱼腥草等经微生物发酵的活性原料;乳酸菌发酵系列包括乳酸菌发酵溶胞产物、舒衡素(乳酸 GABA 发酵液)等。另有枸杞甘草草本发酵特色原料。
电话 / Tel:18665557851
电邮 / Email:shym060@mfsj1908.com
惠思乐:PurTide Zinc 肽欣悦头皮护理活性原料
展位号:3C10

自主研发专利原料(专利号:CN2024113318726),核心成分为酵母菌/锌发酵产物与己二醇。通过抑制 5α-还原酶阻断头皮油脂合成,以多肽与锌复配协同机制从源头阻断头屑生成,可抑制炎症因子分泌缓解头皮敏感,并借助变构调节 CaSR 强化头皮屏障修护。适配驻留类及淋洗类头皮护理产品,添加量 0.5-10%。
电话 / Tel:15262923300
电邮 / Email:sales@wjhealthcare.com
网址 / Web:www.wjhealthcare.com
加新生物:高海拔植物发酵与糖质平台
展位号:2A43

以皮肤微生态美学为基础,依托高海拔植物活性与发酵协同增效。“双菌修颜”系列采用双菌丝体联合发酵,构建天然抗氧化体系,抑制 TNF-α、IL-6、NO 等炎症介质释放。糖质平台以紫花大白芨、滇黄精、桃胶、银耳多糖为核心,结合分级纯化与分子量精准控制,强化成膜保湿与屏障修护。
电话 / Tel:13671796743
电邮 / Email:xianenkemao@126.com
网址 / Web:www.jaxibiotech.com
健元医药:芋螺金刚肽即时抗皱多肽
展位号:3G44

通过 AI 智能设计与定向精准改性开发的新一代芋螺毒素肽类似物,生物活性为传统 μ 型芋螺毒素肽的 10 倍,起效浓度大幅降低。改性后显著提升多肽整体正电荷密度,增强透皮渗透能力,靶向结合骨骼肌 Nav1.4 通道能力更优。兼具舒缓维稳、保湿、修护肌肤屏障等多重功效,实现抗皱与养肤双重突破。
电话 / Tel:86-13632586092
电邮 / Email:wusp@jymedtech.com
网址 / Web:https://jymedtech.com/
锦波生物:ARHC VII 重组 VII 型人源化胶原蛋白
展位号:7L23

率先实现 VII 型胶原蛋白产业化,100% 人体同源性,无非人胶原氨基酸序列,蛋白质结构已收录于 PDB 数据库(ID: 8YUK)。在皮肤中紧邻真皮层上层,向上与 IV 型胶原、层粘连蛋白协同维持基底膜完整性,向下铆钉 I、III 型胶原纤维稳固真表皮连接。可促进 6 种胶原蛋白再生,曾获 PCT 荣格技术创新奖。
电话 / Tel:17300951480
电邮 / Email:info@jinbo-biomed.com
网址 / Web:https://www.sxjbswyy.com
网址 / Web:http://www.jvchem.cn/
巨诚化工:药用层孔菌 SCCX-FOE
展位号:8D49

联合中科院成都生物研究所开发,严选长白山野生层孔菌菌种,采用生物发酵与超声辅助双技术组合。活性物质含量达 80%,三萜类成分含量达 100μg/mL。人体测试显示涂抹 8 小时皮肤相对出油率降低 55%,连续使用 4 天平均毛孔面积减少 27.47%,兼具控油与收敛毛孔功效。
电话 / Tel:13760685696
电邮 / Email:576126717@qq.com
网址 / Web:http://www.jvchem.cn/
晙临生物:CF-977 氧化白藜芦醇
展位号:7L63

提取自桑树的氧化白藜芦醇原料,基于抗氧、抗炎、抗黑三重通路实现多效护肤。酪氨酸酶抑制活性为曲酸的 106 倍、377 的 10.6 倍,可抑制 TNF-α、IL-1β 等炎症因子及 NF-κB 信号通路,同时阻断 TRPV1 通道激活。经超分子纳米增效技术处理后水溶性和生物利用度显著提升,0.2% 浓度下透明质酸酶抑制率达 93.79%。
电话 / Tel:18802064028
电邮 / Email:465460114@qq.com
克琴科技:Anallerg-NFA 麦芽糖酸新一代生物酸
展位号:7A11

依托自主研发的脱氢酶催化工艺制备(专利申请号:202411082455.2),改善传统酸类原料易刺激、肤感粘腻的问题。通过调节 KLK7、Caspase-14、DSC1、DSG1 等关键脱屑与屏障相关蛋白,促进角质有序更新。抗糖能力优于 L-肌肽。功效测试显示使用 4% 精华 4 周后,光泽度提升 24.94%,皮肤弹性系数 R2 提升 31.98%,毛孔面积下降 52.65%。
电话 / Tel:19145713540
电邮 / Email:zhangdie@coachchem.com
网址 / Web:www.coachchem.com
莱宝康Vantage:三款创新功效原料
展位号:8J01

展出三款核心成分:ANGEL-EYE EFX GP 将桑黄与当归根提取物结合,通过激活 LCE3B、CYGB 等蛋白实现眼周年轻化;TUCUM-HA EFX 融合亚马逊星果棕果油与霍霍巴酯,通过内促合成、外防降解双通路提升透明质酸水平;Distinctive Sunbooster 可提升 SPF 值并改善物理防晒剂泛白问题,赋予轻盈肤感。
电话 / Tel:13917872623
电邮 / Email:Iris.Cao@vantagegrp.com
网址 / Web:vantagegrp.com
联合微粉:XSorb 轻感防晒水浆
展位号:2C27

即用型物化防晒预分散体系,采用创新结构乳化专利技术,将多种有机与无机防晒剂稳定整合于水相中。相同防晒剂用量下可实现更高 SPF 与 UVA 防护表现。水浆形态低粘度、易分散,可简化研发与生产流程,成品肤感清爽轻盈,适用于日常防晒及轻质防晒产品开发。
电话 / Tel:13788944036
电邮 / Email:katharine.liu@uni-powder.com
网址 / Web:www.uni-powder.com
淼森股份:Runmild HLC 大分子阴离子烷基糖苷表活
展位号:2A35

采用水酶法绿色工艺,以水为唯一溶剂,7 天生物降解率达 100%。通过阴离子改性提升分子量、降低临界胶束浓度,减少吸附残留与刺激性,改善常规阴离子表活脱脂过强的问题。泡沫耐硬水、稳定绵密,pH 适用范围广,可用于洗发、沐浴、婴童洗护及私密清洁等产品。
电话 / Tel:020-38743652
名花香料:全品类香气解决方案
展位号:3F32

以“时代香气处方”为主题,展示覆盖香水香氛、个护洗护、口腔护理、护肤香精等全品类香气创新方案。重点呈现微胶囊控释技术,实现香气持久与多场景应用。展会现场通过微展览形式,演绎从法国格拉斯天然本源到中国不同时代标志性气息的嗅觉文化演进。
电话 / Tel:19584668868
电邮 / Email:yuanyuan.yang@8flowerflavor.com
纳康生物:ACS 活性物载体系统
展位号:2K32

运用活性物载体系统(ACS)突破活性物应用障碍。光甘草定阳离子脂质体结合阳离子脂质体与多囊脂质体技术,高效利用光甘草定;密丝因环糊精体系实现高包载量可比落、亚美尼斯和咖啡因,为防脱固发提供支持;稳定愈创蓝采用类脂纳米囊搭载 5% 愈创薁,水油两溶易应用。
电话 / Tel:18913169626
电邮 / Email:judy.xu@nanohealth.com.cn
网址 / Web:https://www.nanohealth.com.cn
Provital 璞未:Intensilk 热量限制模拟活性成分
展位号:2K55
首款美妆领域热量限制模拟活性成分,原料源自西班牙果农疏除的苹果花,核心活性成分为根皮苷。模拟脂肪热量限制触发脂噬与脂解,调控脂质代谢抑制脂肪生成。体外实验显示 0.031% 浓度使脂肪囊泡减少 56%,0.063% 浓度甘油释放量提升 194%。人体试验显示 56 天使用后大腿围减少 0.67cm,皮肤弹性提升 18%。已获 ECOCERT、COSMOS 认证。
电话 / Tel:13764626157
电邮 / Email:shuya@weareprovital.com
网址 / Web:www.weareprovital.com/zh/
Roquette Beauté:植物基多功能原料
展位号:8B19

利用可再生植物资源开发高性能、可生物降解原料,产品源自玉米、豌豆、马铃薯和小麦,为配方师提供质地、成膜性和稳定性等关键功能特性。重点展示 Beauté by Roquette ST 730 羟丙基淀粉,源自可持续豌豆淀粉,经临床验证可作为合成成膜剂替代品,提供持久耐水和紧致效果,具有即时提拉效果并可平滑面部皱纹。
电话 / Tel:821053802824
电邮 / Email:JOSCELIN.WONG@roquette.com
网址 / Web:https://roquette.com
湃肽生物:花美锦牡丹提取物
展位号:7A23

采用创新型定向生物酶解技术制备,首先提取高纯度蛋白,再通过自主筛选的高效温和蛋白酶实现活性成分精准释放,工艺过程几乎不使用化学试剂。可促进 I、III、IV、VI 型胶原蛋白生成,提高光聚糖蛋白、纤连蛋白含量。作用机制通过调控 NF-κB/MAPK 信号通
仁恒智研:ZBREPⅡ 三重蛋白屏障修护原料
展位号:6E42

针对受损皮肤屏障(激素依赖性皮炎、湿疹、玫瑰痤疮)开发,采用物理屏障重建与生物活性调节双路径设计。核心成分功能性蛋白均通过第三方功效评价,涵盖细胞修复、皮肤致敏、皮内反应、急性全身毒性等完整测试。适用于激素脸、光电微创术后、敏感肌肤等场景。
电话 / Tel:13318325168
电邮 / Email:liu_siyi@sdkindscience.com
网址 / Web:www.sdkindscience.com
锐兴化工:Repoly APT 高耐电解质增稠剂
展位号:7B54

专为严苛电解质体系设计的高效增稠剂(聚丙烯酰基二甲基牛磺酸铵),凭借精密交联结构,在 pH 4-9 范围内实现稳定增稠,尤其适用于含果酸、水杨酸等酸类活性成分的祛痘及美白产品。肤感厚实温润,是继 Repoly AVP、Repoly SHP 之后在聚合物精准交联技术领域的新突破。
电话 / Tel:15521240871
电邮 / Email:grace@reachinchem.com
网址 / Web:www.reachinchem.com
瑞德林:ReOilin-Pro 4310 油溶多肽抗皱原料
展位号:7H23

采用 LipiRevX 技术实现水溶活性物在油相中的稳定包载与智能递送,填补纯油溶产品无法添加水溶活性原料的空白。含乙酰基六肽-8、类蛇毒肽、精氨酸/赖氨酸多肽三重神经肽,通过前、中、后端全方位抑制神经信号传导抵抗动态纹;乙酰基四肽-9 促进胶原正确组装抵御静态纹。核心活性成分获欧盟 COSMOS 及清真 Halal 认证。
电话 / Tel:0755-26659310
电邮 / Email:zhangyueyang@szreadline.com
网址 / Web:https://www.szreadline.com
润辉生物:透美诺 VCHA 抗坏血酸透明质酸酯
展位号:7J53

依托融合分子皮肤渗透技术平台开发的维生素 C 衍生物,将 VC 与透明质酸相结合,攻克原型 VC 易氧化、失活、变色难题。经皮肤酯酶缓慢分解释放活性成分,实现长效缓释;pH 接近中性,刺激性远低于传统 VC。具备高稳定性与优异渗透性,可应用于膏霜乳液喷雾等多种剂型。
电话 / Tel:13570352487
电邮 / Email:sales@rltbio.cn
网址 / Web:www.rltbio.cn
森瑞斯:全生物合成高纯度角鲨烷
展位号:6H28

构建 AI 计算、自动化平台、菌株开发、工艺放大全链路合成生物平台。角鲨烷采用全生物合成工艺,通过关键酶突变体筛选及纯化工艺优化,产品纯度高于 98%,无杂质,高生物安全性。具有优异亲肤性、稳定性与渗透性,适用于保湿、修护及婴童护理等领域。
电话 / Tel:0755-26881685
电邮 / Email:marketing@synceres.com
网址 / Web:https://www.synceres.com
圣诺生物:CycloLock 环肽-113
展位号:6H43

首创“钥匙肽”结构,将功效互补的环肽与线性肽精准偶联,实现协同增效。环肽部分借鉴核转运靶向药物设计,通过竞争性抑制核转运蛋白 α3 阻断 NF-κB 核转位,从源头干预炎症级联反应。可同步作用于炎症、屏障、神经敏感与色素沉着四大通路,系统性改善敏感肌问题。
电话 / Tel:19138954506
电邮 / Email:lola_miao@hotmail.com
网址 / Web:https://www.snbiopeptide.com/
司马因泰聚合物:ZETESAP 天然固态氨基酸表活皂
展位号:8B02

展出 ZETESAP 813P 和 ZETESAP 915 CS 两款产品,均不含皂基,采用植物或植物基来源成分,获天然认证和 COSMOS 认证。具有卓越起泡性能,温和清洁不刺激。ZETESAP 915 CS 弱酸性 pH 值与人体皮肤相近,兼容几乎所有香型。固体形态无需额外塑料包装,可在激光和去角质后使用。
电话 / Tel:183 1001 9913
电邮 / Email:simon.guo@interpolymer.com.cn
网址 / Web:www.zschimmer-schwarz.com
斯拜科:槐糖脂系列产品
展位号:7K18

微生物发酵来源的糖脂类生物表面活性剂系列。SpecBio SL D600 具有保湿、抗菌、抗炎、修复功效;SpecBio SL D500 可作为表面活性剂、清洁剂、增溶剂使用;PrzvFree SL 415 为天然来源复配防腐剂,符合 COSMOS 认证标准;SpecKare HC 401 由小分子蛋白、氨基酸、肌肽和糖脂组成,针对受损发质开发。
电话 / Tel:+86 25-8452 3390/8452 3391
电邮 / Email:zhangchunyan@specchem.cn
网址 / Web:www.specchemind.com
维琪科技:WKPep Ahatide 果酸肽
展位号:2C36

2025 年 7 月备案的新原料(国妆原备字 20250089),通过靶向干预角质桥粒的组装与形成实现仿生剥脱焕肤。模拟桥粒结构关键位点,优先与桥粒胶蛋白结合,阻止老旧角质细胞间连接,促进自然脱落。作为“0 酸”小分子胜肽,避免传统剥脱带来的刺激、泛红、脱皮等问题,无需建立耐受,敏感肌可用。
电话 / Tel:18124178493
电邮 / Email:youlili888@winkey-china.com
网址 / Web:http://www.winkey-china.com/cn/
仙婷:熠米粏 SRA 超共生代谢物后生元
展位号:2C07

新一代后生元,源自越光糙米多真菌共发酵,获 COSMOS-APPROVED 认证。通过 AI 辅助网络药理学分析,将 1000+ 种代谢物与 500+ 个皮肤靶点关联,多通路协同作用于黑色素生成、线粒体功能、表皮及 DEJ 层修护。临床实证显示 2% 浓度与丁基间苯二酚美白等效,同时 4 周内光泽度提升 26.19%;3% 浓度 2 周显著减少 83% 细纹及 47% 法令纹。
电话 / Tel:+86 20 8769 0889
电邮 / Email:info@sethic-innovations.com
网址 / Web:www.sethic-innovations.com
先达医药:SynTide CP100 太子参环肽
展位号:6C19

由多个氨基酸首尾相连的环八肽,无游离 N 端和 C 端,结构稳定性高。可促进 I 型、III 型胶原蛋白合成,改善胶原组织结构。体外测试显示 0.3% 浓度下 Collagen I、III 基因表达分别上调 80.56%、70%;人体测试显示使用含 1% 该成分产品 28 天后眼角皱纹面积下降 23.56%,眼下皱纹面积下降 21.83%。
电话 / Tel:025-58201365
电邮 / Email:Nancy.lee@syInta.com
网址 / Web:www.sylnta.com
心萃善植:金耳菌素
展位号:以现场为准

新鲜金耳纯水提取冻干,极大限度保留多糖(80±10%)、蛋白与核酸等活性物质。可促进人 β-防御肽 2(HBD2)表达,调节致病菌与有益菌平衡,对人体损伤屏障进行有效修护。
电话 / Tel:15671788773
电邮 / Email:shuzixuan@senseseeds.cn
新斯浦:包裹体技术创新原料
展位号:3K09

展出变色粒子、可溶粒子、磨砂粒子、仿生花瓣、仿生蚕丝、柔珠及油性鱼子等多种创新原料。变色粒子为高浓度色淀微囊,抹开时展现内部颜色;可溶粒子可包裹活性成分并通过溶解释放;油性鱼子实现水油可视化与活性物包裹。采用流化床微丸包衣及高端微射流胶囊包裹技术。
电话 / Tel:020-29075635 / 13711584860
电邮 / Email:2929936970@qq.com
网址 / Web:http://www.xinsipu.com.cn
益瑞石:ImerCare 天然云母无滑石粉彩妆原料
展位号:8D22

PCHi 2026 首发两款高性能天然云母新品。ImerCare Mica SE 5 专为散粉配方开发,赋予粉体丝滑细腻的奶油触感,增强妆面亮度与通透感,具备良好控油能力。法国原产 ImerCare MicaSilk 针对压粉类产品优化,解决非滑石粉配方压实难、易碎裂问题,片状结构可柔焦毛孔和细纹。两款产品均 100% 源自天然矿物,符合全球清洁美妆标准。
电话 / Tel:(+86) 131 6234 5652
电邮 / Email:Anna.Chen@imerys.com
网址 / Web:https://www.imerys.com/zh-hans/china
云南西草:CoffeMyco 5D 五维抗衰复合原料
展位号:3L31

以云南咖啡、松茸与黑松露三大天然可食用原料为核心,基于独家专利低温小分子水基(L-TSM)非热萃取技术开发。以小分子团簇水为溶剂在低温条件下完成提取,最大程度保留多糖、咖啡因及麦角硫因等关键功能物质的生物活性。构建覆盖抗氧化、抗炎、真皮结构修护、色素调控及屏障修复的五维抗衰通路,相关功效数据均通过第三方验证。
电话 / Tel:19511269574
电邮 / Email:1538677838@qq.com
网址 / Web:https://www.yunnanxicao.com/sy
云南西草:CoffeMyco 5D 五维抗衰复合原料
展位号:3L31

以云南咖啡、松茸与黑松露三大天然可食用原料为核心,基于独家专利低温小分子水基(L-TSM)非热萃取技术开发。以小分子团簇水为溶剂在低温条件下完成提取,最大程度保留多糖、咖啡因及麦角硫因等关键功能物质的生物活性。构建覆盖抗氧化、抗炎、真皮结构修护、色素调控及屏障修复的五维抗衰通路,相关功效数据均通过第三方验证。
电话 / Tel:19511269574
电邮 / Email:1538677838@qq.com
网址 / Web:https://www.yunnanxicao.com/sy
长沙普济:氨基酸衍生物系列原料
展位号:2A23

展出多款专利氨基酸衍生物原料:月桂酰赖氨酸作为肤感调节剂,赋予皮肤柔软丝滑感,提升配方均匀度;月桂酰肌氨酸异丙酯可溶解防晒剂等难溶组分,低粘度触感轻盈;辛酰甘氨酸具有控油和保湿修复效果,可减少头屑产生;二棕榈酰羟脯氨酸采用专利工艺制造,刺激胶原蛋白重排;十一碳烯酰基苯丙氨酸低浓度即可发挥美白效果。
电话 / Tel:0731-83285395
电邮 / Email:info@pujibio.com
网址 / Web:http://www.pujibio.com/
甄萃:植物愈伤组织+超酶自融技术原料
展位号:3A22

结合植物愈伤组织与超酶自融技术实现高活性成分温和、稳定与高效渗透。甄莲舒(穿心莲叶提取物)靶向抗炎,即时舒缓皮肤泛红痛痒,从源头阻断炎症反应;甄肌瓷(石榴果鞣花酸)通过愈伤组织培养提升鞣花酸水溶性与生物利用度,抑制炎症后色素沉着;精炼深海鱼油实现无色无味透明液体,补充肌肤必需脂质修复屏障。
电话 / Tel:13802800842
电邮 / Email:54996415@qq.com
植纳生物:愈肤茵中草植萃舒缓原料
展位号:2K51

以河南道地马齿苋与“浙八味”浙玄参为核心成分,经专利工艺精制的无添加冻干粉。精准作用 TRPV-1、IL-1α、组胺三大靶点,构建全链路炎症抑制体系。可促进丝聚蛋白、神经酰胺、透明质酸等屏障关键成分合成。临床测试显示 0.5% 浓度可 2 分钟缓刺痛、5 分钟减泛红、30 分钟退炎症风团。
电话 / Tel:15221053658
电邮 / Email:yuan-fu@laibo.com.cn
网址 / Web:http://www.zhinakeji.com/
中科中植:Tangola 秦艽抗敏原液
展位号:3F06-3

源自海拔 2600 米以上青藏高原超净区的秦艽植物,通过水提法纯净萃取,富集环烯醚萜苷类标志性活性成分(龙胆苦苷+马钱苷酸)。核心技术创新在于“双信号双通路双靶点”抗敏机制,已获国家发明专利。精准靶向抑制 iNOS、IL-1α/β、IL-6、IL-8 及 NF-κB 等关键炎症信号,原料符合中国药典标准。
电话 / Tel:17757285679
电邮 / Email:185617801@qq.com
网址 / Web:www.zhongkezhongzhi.com
卓科生物:朝颜幻色粉体
展位号:2F36

华熙生物全资子公司携手伊露珂推出,采用透明质酸水凝膜包裹变色活性物的核心技术。粉体干燥静置时呈纯净白色,遇硅油浸润即刻呈现柔和淡紫色,接触皮肤分泌的油酸后转化为自然肉粉色。可吸附皮肤多余油脂实现精准控油,同时维持底妆清透质感,实现控油持妆与气色焕升双重功效。
电话 / Tel:13602277516
电邮 / Email:information@hismartbiotech.com
实验室及产品服务
环特生物:斑马鱼及多维生物技术功效评价平台
展位号:8H63
健康美丽产业 CRO 服务开拓者,首次将斑马鱼技术从基础研究大规模应用于化妆品功效与安全性评价,实现国内首例基于斑马鱼实验报告的化妆品功效备案。打造中国首家用于化妆品开发的人源皮肤外植体产业化研究平台,融合细胞、类器官、斑马鱼、哺乳动物、皮肤外植体和人体临床多维生物技术,提供从原料筛选、配方研发、功效安全评价到产品备案的一站式解决方案。
电话 / Tel:13456759302
电邮 / Email:357568330@qq.com
网址 / Web:www.zhunter.com
欧易生物:质谱成像功效成分透皮吸收可视化平台
展位号:以现场为准

利用高通量、免标记的原位质谱成像技术,在人离体皮肤模型中实现多成分透皮吸收、代谢转化及细胞内源性代谢响应的同步可视化分析。兼具定性、定量、定位功能,可精准判断成分透皮层次(角质层、表皮层、真皮层),追踪代谢途径,揭示功效机理。联合国内外权威机构发布本领域国内外首个团体标准,并布局多项核心专利。
电话 / Tel:15316103923
电邮 / Email:fangming.tu@lumingbio.com
网址 / Web:www.oebiotech.com
分销商
佰利欣:八樽植萃中药头皮护理原浆
展位号:6D16

脱胎于《本草纲目》《古今医鉴》等千年医典,承袭“君臣佐使”配伍精髓,遵循“清-活-养”三步进阶。集结侧柏叶、何首乌、皂角、无患子、浮萍、当归、川芎、香附八大本草精华,以古法配伍融合现代膜萃绿色工艺,先净澈、舒缓头皮、后滋养发根。
佰斯特/彗柏:多维共组装微流递送平台系列原料
展位号:7H23

展出三款基于 HauteDeliv 多维共组装微流递送平台的创新原料。欧舒因将燕麦碱水溶性提升 1000 倍,透皮效率提升 310%,30 秒内降低 41% 乳酸刺痛;维粒因通过充能、供能、储能三位一体提升细胞内源性 ATP,人体测试显示表观年龄年轻化 6.7 岁;欧密盈将稀有人参皂苷与辛酰甘氨酸在分子水平精准组装,双核靶向控油防脱。
电话 / Tel:13640185613
电邮 / Email:marketing@bst.email
柏燿生物:丝心蛋白及生物材料系列
展位号:2C12

展出六大特色产品。丝心蛋白源自天然蚕茧,可调节分子量特性衍生出活性水溶液、活性乳液、酶解滤液、冻干粉等多款产品,丝心蛋白可溶微晶能无痛快速建立皮肤微通道实现透皮促渗。另有中草药发酵油、反胶束包裹油(可包裹水溶/油溶性活性成分提升稳定性和渗透性)、植物源防腐剂、透皮环肽及植物源食品级乳化剂系列。
电话 / Tel:18122102309
电邮 / Email:bioyoung@126.com
网址 / Web:http://www.gzbioyoung.cn
肤莱特:场景赋能功效原料解决方案
展位号:7C24

以“场景赋能、新品突破、功效实证”三大板块参展。重点新品包括:Eamoist DO 多功能润肤脂,调控粉体分散优化成膜结构,提升防晒效能与彩妆贴肤质感;Efficactive Plank EX 源自法国微藻诱导培养技术,靶向 CPD 和 TXNIP 实现 DNA 修护与抗氧化;另有 Reflez PCA GO、Vital et sp 维易净肤因子、Efficactive collanight 等新品。
电话 / Tel:13814858896
电邮 / Email:shenqz@richori.com
康顺新能源:高端异构烷烃溶剂系列
展位号:8A45

展出埃克森美孚 ISOPAR G/H/L/M、日本出光 LX、异构十二烷、GT-103、TD 及天然 D-柠檬烯等产品。采用国际先进加氢异构化技术精制,纯度≥99.5%,低芳烃(≤0.01%)、低气味、零 VOC,挥发速率精准可控,干燥后无残留。可替代高污染芳烃溶剂,符合 REACH、SGS、ISO9001 认证,适用于彩妆护肤、卸妆、香薰等领域。
电话 / Tel:137 5130 5945
电邮 / Email:tanxinyou@kangshun.cc
网址 / Web:www.kangshun.cc
龙慧贸易/航森贸易:锐伊纯红没药醇及功能蛋白系列
展位号:7F02

核心产品锐伊纯红没药醇获 COSMOS 认证,采用玉米糖发酵工艺,100% 天然来源,单一构型左旋结构,可抑制马拉色菌异常增殖,实现控油抑屑、维稳头皮屏障功效。同时展出锐青因麦角硫因、舒妍安神经酰胺 NP、如甄系列功能蛋白(纤连蛋白、弹性蛋白、胶原蛋白 IV、乳铁蛋白)等多款原料。
电话 / Tel:13539884026
电邮 / Email:julia@longhuigd.com
网址 / Web:www.longhuigd.com
乾飞/荣道:路博润及素莱碧雅功效原料
展位号:2F32

代理路博润、素莱碧雅等国际知名企业产品。重点展出:Argireline Amplified 六胜肽 PRO,从皮肤六个维度起效,可延长肉毒效果 4 个月;Uplevity e-Lift 立次元肽,与微电流美容仪靶点相同,实现全脸提拉;FUCOGEL 生物糖胶-1,5 分钟即时舒缓;RHAMNOSOFT HP 生物糖胶-2,30 分钟褪红,聚焦神经-免疫-皮肤系统。
电话 / Tel:13402131128
电邮 / Email:marketplace@roundex.com.cn
网址 / Web:http://www.roundex.com.cn/
润友新材料:Supcare HM 结晶型稳定剂
展位号:6B09

独特的结晶型稳定剂,应用于皂基体系可达到双结晶效果,协助形成更多 γ 结晶,使体系具有较高硬度和良好溶解性。应用于氨基酸洁面乳可提高层间距,容纳更多多元醇,提高结膏点,避免高温出水。应用于洗发香波可调节絮凝状态,提高絮胶饱水量。具有悬浮稳定硅油、粒子、散粉、ZPT 等效果,不惧任何 pH 值。
电话 / Tel:18820021304
电邮 / Email:18820021304@163.com
网址 / Web:http://www.gzrunyou.cn/
上海百好博:智能递送与神经酰胺矩阵解决方案
展位号:7C37

以“美丽无界•迎潮而动”为主题,展出 11 个场景化解决方案。亮点产品包括:Golden C NG 金微粒递送体系搭载原型 VC 与谷胱甘肽,5000 倍放大 VC 活性;MatriGold NG 黄金肽科技搭载棕榈酰五肽-4;X50 NeoSyno-Col 双肽精准协同;赢创神经酰胺矩阵涵盖 30+ 种产品;以及三种不同来源 PDRN 和瑞德林油溶肽系列。
电话 / Tel:021-54175512
电邮 / Email:shirley.sun@biohope.com.cn
网址 / Web:www.biohope.com.cn
圣凯西:PDRN、蜂王浆多肽及牡丹系列
展位号:3F10

展出三大系列原料。PDRN 源自阿拉斯加野生太平洋狗鲑,与人类 DNA 同源性达 98%,采用妆械同源温和工艺提取;PhyTorpe ROY 蜂王浆多肽源自长白山椴树蜜蜂王浆,采用生物酶解工艺提取小分子活性肽;牡丹系列甄选山东菏泽优质白牡丹,涵盖牡丹花水、牡丹根提取物、牡丹籽油、牡丹发酵油。
电话 / Tel:+86 21 6475 0191
电邮 / Email:yuting.hao@sunkisschemical.com
网址 / Web:http://www.sunkisschemical.com/
万明生物:SkinEase 天然低共熔靶向渗透技术
展位号:3E39

推介南京毓浠医药研发的天然低共熔溶剂(NaDES)透皮递送技术,透皮效率可提升 6-30 倍,已获 10 余项国内外发明专利。成熟原料包括:IDT-101 30% 玻色因增强复配液,皮内滞留量达市售产品 12 倍以上;IDT-102 30% 水溶壬二酸复配液,人体测试显示 14 天粉刺减少 44.8%;IDT-103 大分子促透复配液,透皮吸收量提升 20-30 倍。
电话 / Tel:13764395988
电邮 / Email:wlymp@sina.com
至柔化工:PICKMULSE 皮克林乳化剂
展位号:2F20

不含表面活性剂的乳化剂,具有柔软的粉质感,已获配方应用专利。运用皮克林技术为彩妆打造独特外观与使用效果。INCI 为淀粉辛烯基琥珀酸钠,呈白色光泽质感,稳定性强,可提供长效肌肤保护与柔软粉质感。
电话 / Tel:13917109384
电邮 / Email:muguishu@zhirou.com.cn
以上为部分展商展品节选,更多展品预览、展会资讯及深度报道,欢迎扫描二维码访问荣格工业资源网 PCHi 展会专题页:

来源:荣格-《国际个人护理品生产商情》
原创声明:
本站所有原创内容未经允许,禁止任何网站、微信公众号等平台等机构转载、摘抄,否则荣格工业传媒保留追责权利。任何此前未经允许,已经转载本站原创文章的平台,请立即删除相关文章。

